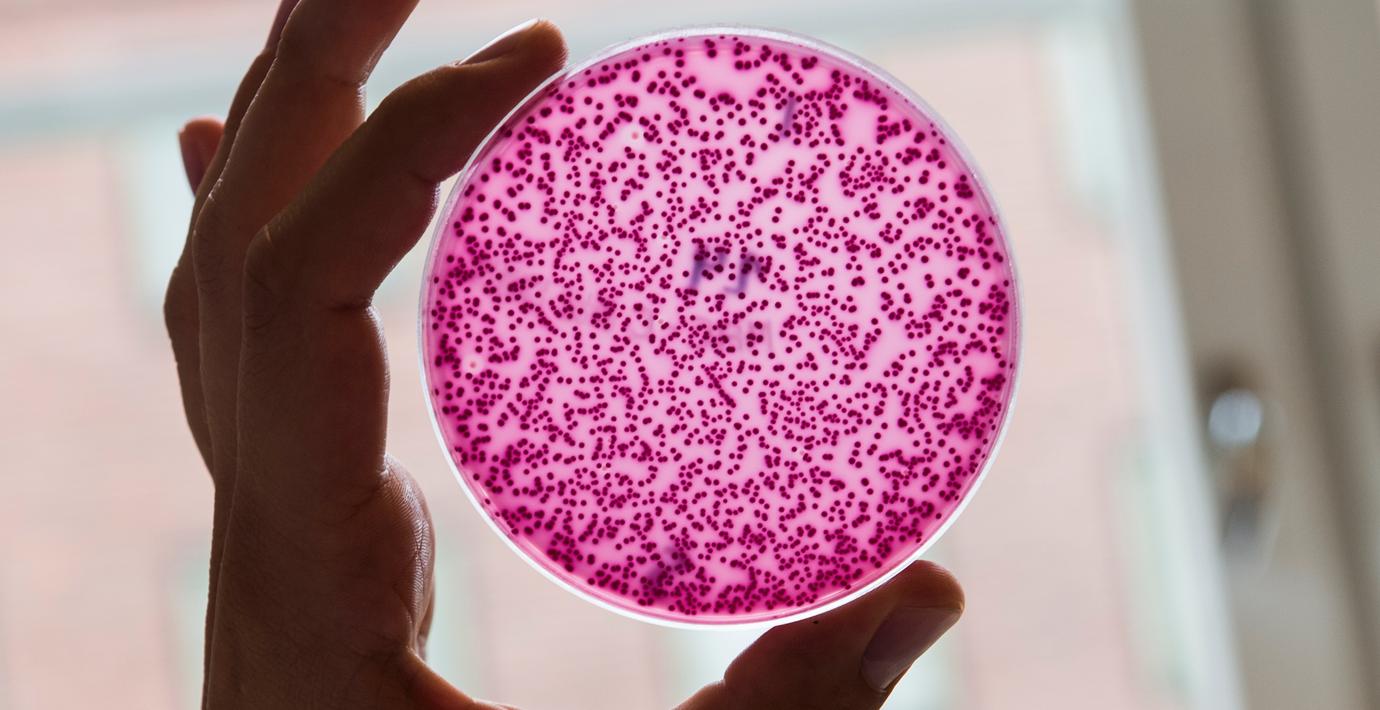

”Miljontals kan dö om ingen ny antibiotika tas fram”
Vid sidan av klimathotet är de resistenta bakterierna troligen det allvarligaste hotet mot mänskligheten. Det skriver Bo Könberg, rapportör till Nordiska ministerrådet och före detta sjukvårdsminister (FP), i ett inlägg på DN Debatt.
Han föreslår att det inrättas en global fond för att få fram nya antibiotika och ny teknologi för att sätta stopp för de resistenta bakterierna. Annars riskerar utvecklingen att leda till över 10 miljoner döda per år, varnar han.
”Jag förselår att den rika världen, främst EU, Nordamerika och Japan, under de kommande fem åren anslår sammanlagt cirka 75 miljarder kronor för att påskynda och underlätta framtagandet av nya antibiotika, bland annat genom att inrätta priser till dem som lyckas. För Nordens länder skulle detta handla om cirka 2 miljarder kronor på fem år, för Sveriges del mindre än en miljard”, skriver Könberg.



